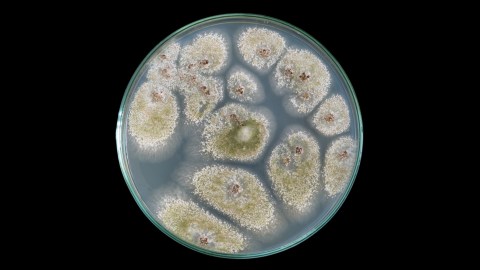

If You Want to Grow a Young Scientist, Here’s a Simple Thing to Try
Image source: kwuanchai.c/Shutterstock
Young children are always getting into things, and grownups are always trying to stop them. As Neil deGrasse Tyson puts it, “We spend the first year teaching them to walk and talk, and the rest of their lives telling them to shut up and sit down.”
It’s a big mistake, deGrasse Tyson points out to any parent wondering how to get their child interested in science. With kids being so curious naturally, how about letting go a little: Let them pluck that petal, play with that fragile egg, or peer under that rock.
The key to raising a scientist, deGrasse Tyson says, is encouraging a young person’s curiosity, not teaching them how to control it. He advocates helping kids explore their world.
So what could be more fitting than a parental experiment designed to pique a child’s interest? deGrasse Tyson has one in mind. If you have a pair of binoculars around, just leave them — without comment — where your child can find them, and watch how his or her horizon expands.

Image source: CasparGirl
If your inclination is to go in the opposite direction, try a magnifying glass.)
After all, for an 11-year old deGrasse Tyson growing up in NYC, it was a pair of binocs that first led his eyes upward through buildings to the open skies, a wondrous moon, and eventually his career.





